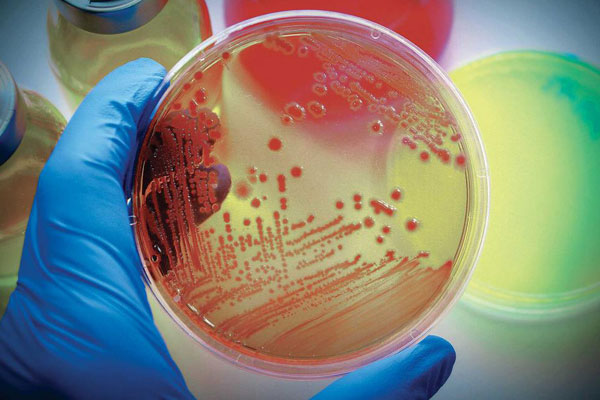
pic_1

Архив
27.12.2021
ПРИГЛАШАЕМ К УЧАСТИЮ ВО ВСЕРОССИЙСКОЙ НАУЧНО-ПРАКТИЧЕСКОЙ КОНФЕРЕНЦИИ «ФУНДАМЕНТАЛЬНЫЕ И ПРИКЛАДНЫЕ АСПЕКТЫ МИКРОБИОЛОГИИ В НАУКЕ И ОБРАЗОВАНИИ»
Кафедра микробиологии ФГБОУ ВО РязГМУ Минздрава России приглашает принять участие студентов, аспирантов и специалистов медицинского, биологического, ветеринарного и сельскохозяйственного профиля во Всероссийской научно-практической конференции с международным участием «Фундаментальные и прикладные аспекты микробиологии в науке и образовании».
Конференция состоится 25 и 26 мая 2022г. Более подробная информация представлена в информационном письме.